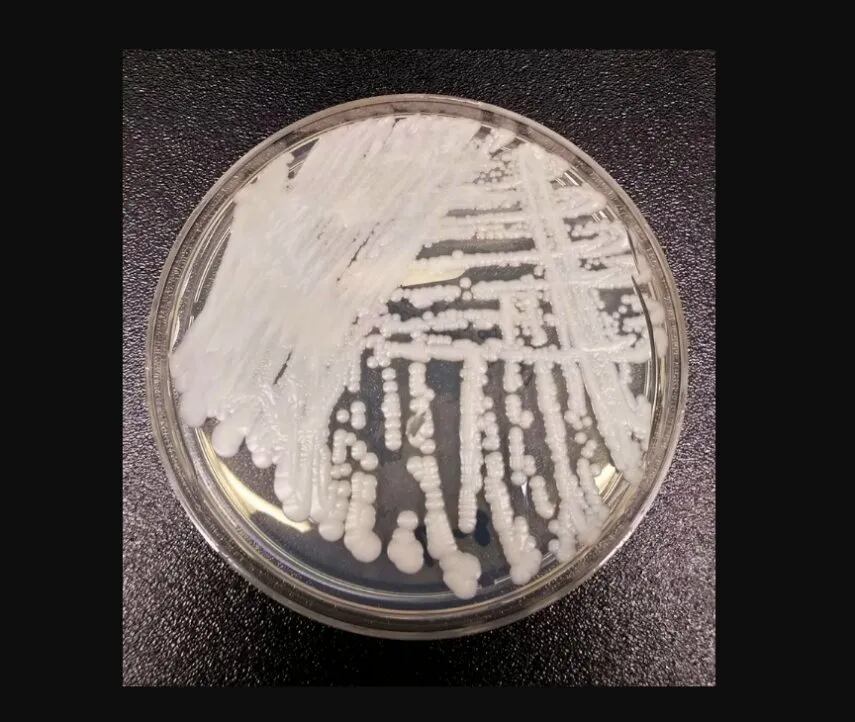
Vista microscópica del hongo.

Aunque no es un hongo nuevo, alarma que los casos de pacientes con Candida auris han aumentado con una rapidez que preocupa a las autoridades de salud de Estados Unidos.
“Es un hongo que causa infecciones graves y que se propaga en centros de atención médica. Los expertos en prevención de infecciones, así como el personal de atención médica y de laboratorio, pueden juntos ayudar a prevenir su propagación”, explican los Centros para el Control y Prevención de Enfermedades, (CDE) de Estados Unidos.
Ahora, las alertas tampoco son nuevas, ya en 2021 la Organización Panamericana de la Salud (OPS) había emitido una alerta epidemiológica motivada por el aumento de brotes de Candida auris asociados a la atención sanitaria en el contexto de la pandemia por la COVID-19.

¿Por qué es la Candida auris un problema?
A pesar de que se conoce su afectación y hay antecedentes de cómo tratarlo, a las autoridades de salud les preocupan cinco aspectos.
- Causa infecciones graves. La auris puede causar infecciones invasivas sanguíneas y de otros tipos, especialmente en los pacientes que están internados en hospitales y hogares de ancianos y que tienen muchos problemas médicos. Más de 1 de cada 3 pacientes mueren dentro del mes de haber recibido el diagnóstico de una infección invasiva por C. auris.
- Con frecuencia, es multirresistente. Los medicamentos antimicóticos que comúnmente se usan para tratar otras infecciones por Candida con frecuencia no tienen efecto en la auris. Algunas cepas aisladas de C. auris son resistentes a las tres clases principales de medicamentos antimicóticos.
- Se está volviendo más frecuente. Si bien la auris tan solo se descubrió en el 2009, la cantidad de casos ha aumentado rápidamente. Desde entonces, se ha reportado en docenas de países, incluidos los Estados Unidos.

- Es difícil de identificar. La C. auris puede ser identificada de un modo erróneo como otro tipo de hongo, a no ser que se usen métodos especializados de laboratorio. Identificar la C. auris correctamente es crucial para dar inicio a las medidas destinadas a detener su propagación y prevenir los brotes.
- Puede propagarse y causar brotes en centros de atención médica. Como ocurre con otros organismos multirresistentes, como las enterobacterias resistentes a los carbapenémicos (ERC) y los Staphylococcus aureus resistentes a la meticilina (SARM), la C. auris puede transmitirse en los entornos de atención médica y causar brotes. Puede colonizarse en pacientes por muchos meses, perdurar en el ambiente y resistir algunos desinfectantes que comúnmente se usan en los centros de atención médica.

Además, explica la Organización Mundial de la Salud (OMS) que “los patógenos fúngicos representan una gran amenaza para la salud pública, ya que son cada vez más comunes y resistentes al tratamiento con solo cuatro clases de medicamentos antimicóticos actualmente disponibles”.

Contexto de la noticia
El 20 de marzo, los Centros para el Control y la Prevención de Enfermedades (CDC) dieron a conocer que el hongo se está propagando de un modo alarmante. En más de la mitad de los 50 Estados que competen al territorio está presente el microorganismo. Con base a sus investigaciones, se han venido duplicando el número de pacientes y triplicando los casos resistentes de equinocandinas, el tratamiento de primera línea que se lleva a cabo para controlar la afectación.
Este contexto resulta ser la tercera vez que los casos se disparan. Entre 2016 a 2018, la cifra pasó de 56 a 330 y, el periodo correspondiente a 2019-2021, el número pasó de 476 a 1.471. Eso quiere decir que, cada tres años, la situación toma fuerza. El año pasado registraron 2.377 infecciones.

La propagación del brote ocurre en los propios centros médicos, dado que el grupo Candida hace parte de la familia de los microrganismos multirresistentes. Puede colonizar a los pacientes durante meses, perdurar en el ambiente y resistir a los desinfectantes. En ese orden de ideas, las recomendaciones son las siguientes para los centros médicos:
- Notificarle a un laboratorio la presencia del hongo, con base a las sospechas o estudios confirmados.
- Iniciar con un proceso de vigilancia, establecido por el laboratorio y que planteará un protocolo para seguir al pie de la letra.
- Tener en el radar a los pacientes con mayor riesgo de infección o colonización asintomática, para brindarles una protección especial. Estos incluyen: Personas que hayan recibido atención médica en establecimientos de cuidados postagudos y pacientes hospitalizados recientemente fuera de Estados Unidos (en especial en países donde el hongo se desarrollo.
- Luego de eso, el siguiente paso es tener un plan de respuesta, el cual hace parte del protocolo del laboratorio. En este, tienen que estar las recomendaciones para la prevención y control de las infecciones, tanto para pacientes como para el cuerpo médico.
- Cabe mencionar que si se necesita transferir un paciente desde el establecimiento a otro, o se les dará el alta de salida; el centro médico debe comunicarle esto al laboratorio, para que se lleve a cabo un plan especial para corroborar que la persona no es un actor con posibilidad de contagiar, sino que no tiene indicios del hongo.

